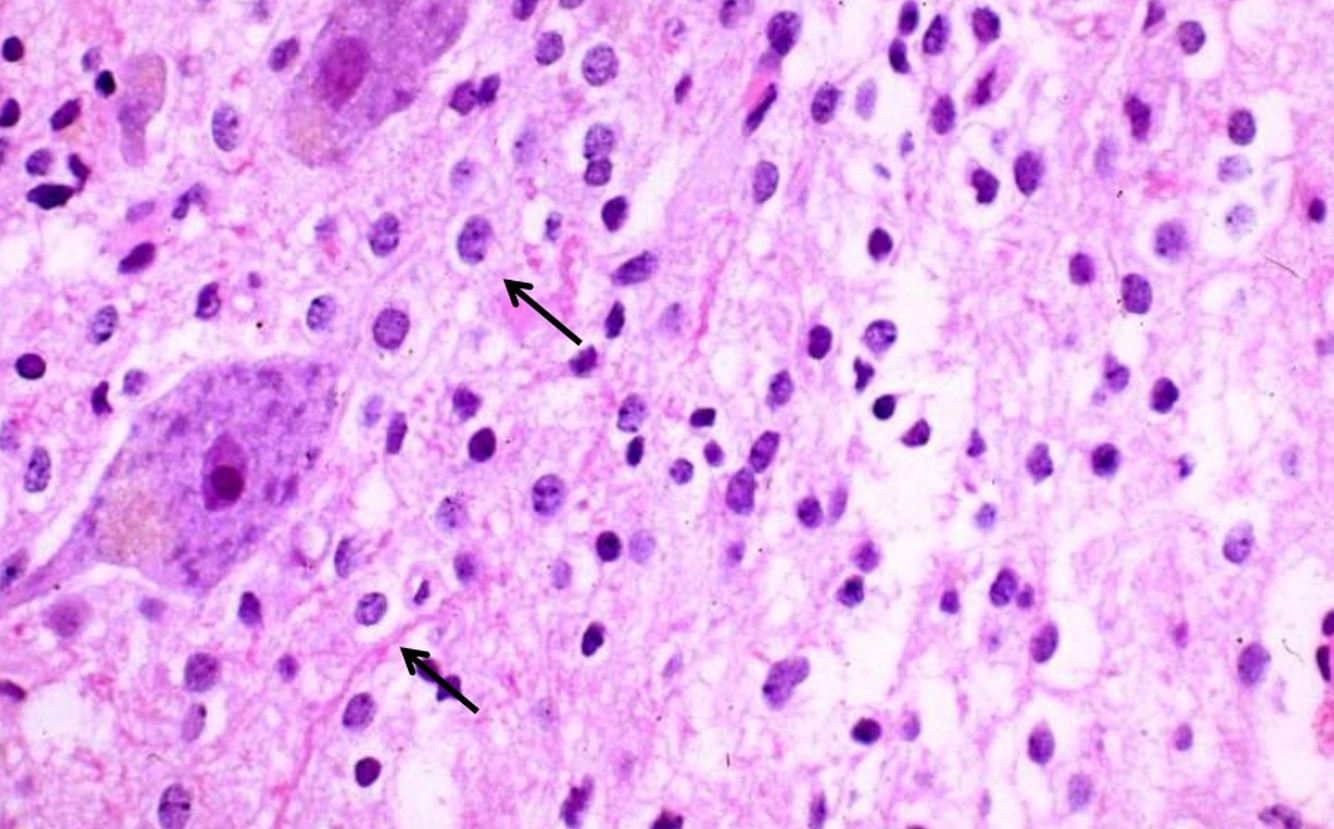
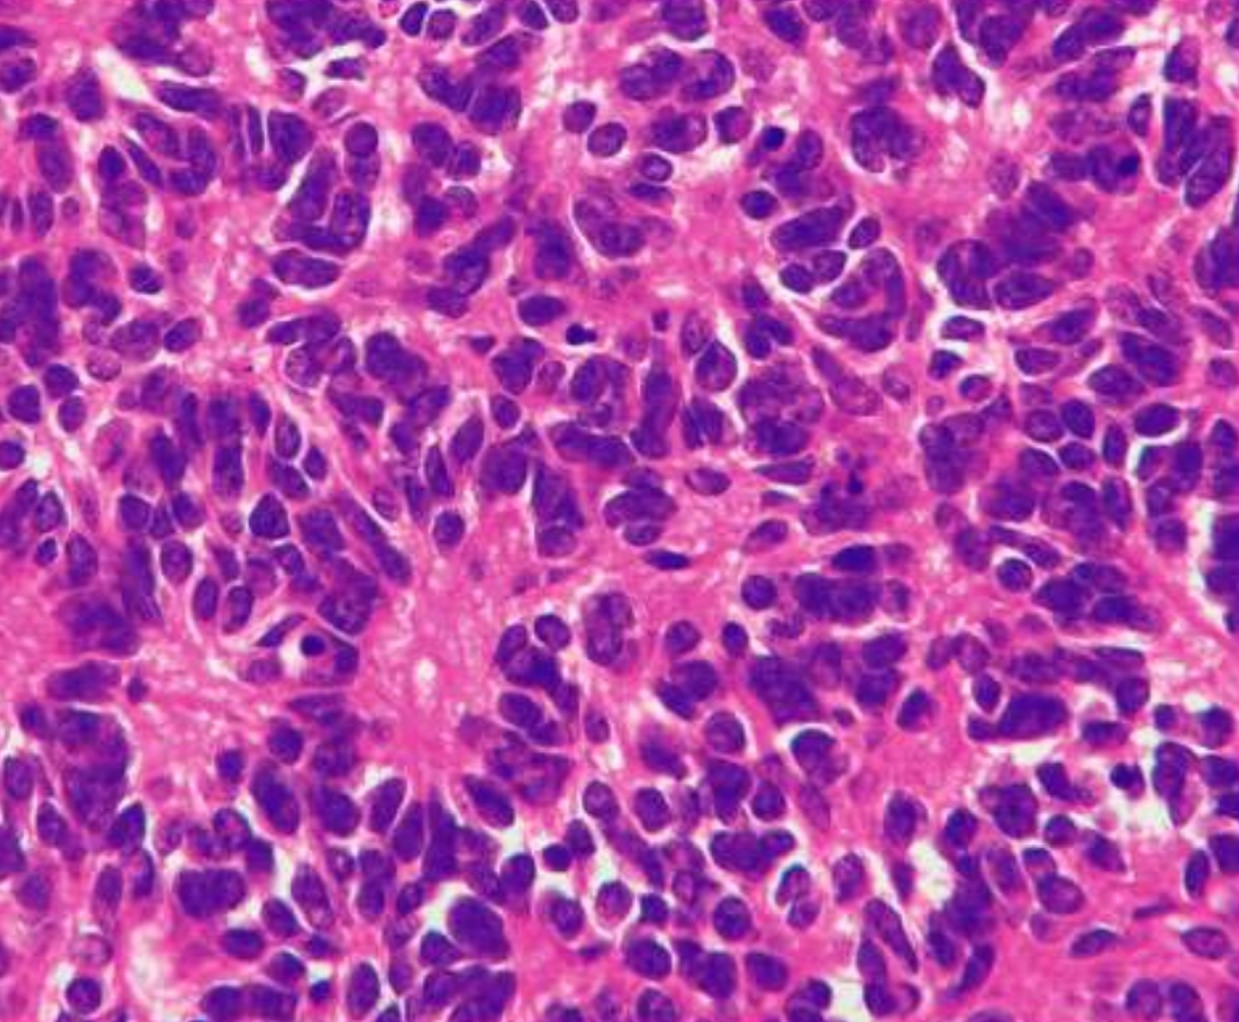

GLIOMAS
GLIOMAS
Astrocytomas
Astrocytomas
Infiltrating Astrocytoma
Infiltrating Astrocytoma





Glioblastoma, WHO grade IV
Astrocytic Genetics
Astrocytic Genetics

Gemistocytic astrocytoma
Non-infiltrating Astrocytomas
Non-infiltrating Astrocytomas

Pilocytic astrocytomas, WHO Grade I
Oligodendroglioma


Ependymoma


Neuronal/Glioneuronal Tumors
Neuronal/Glioneuronal Tumors

Ganglioglioma, GI
Poorly Differentiated/ Embryonal Tumors
Poorly Differentiated/ Embryonal Tumors
– Medulloblastoma
– Primitive Neuroectodermal tumor of the Central Nervous System (PNET)
– Atypical Teratoid/ Rhabdoid Tumor (ATRT)

Medulloblastoma
Primitive Neuroectodermal Tumor



Atypical Teratoid/Rhabdoid tumor

Meningioma

Meningioma Grades and subtypes
Meningioma Grades and subtypes

Anaplastic Meningioma

Clear Cell Meningioma